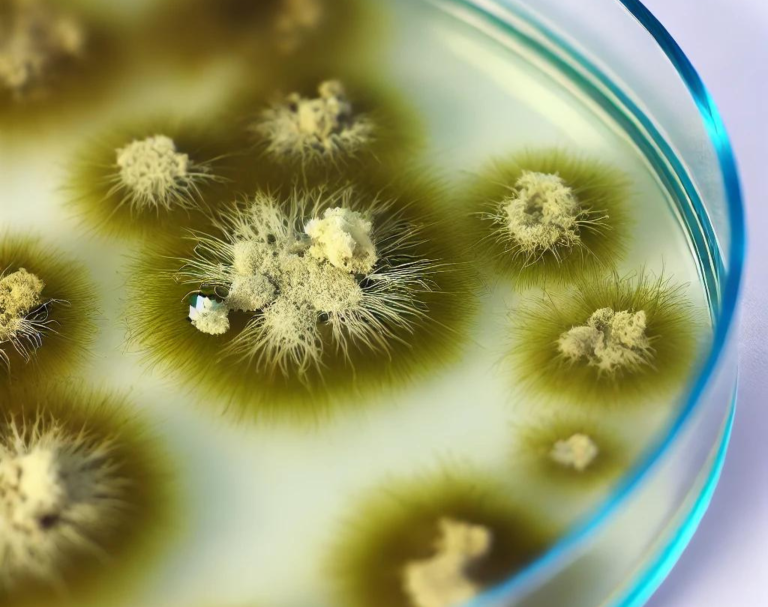

Lion Gruppe
Molekularbiologie
Über die Forschungsgruppe
Die 1989 gegründete Abteilung Molekulare Mikrobiologie der St. Anna Kinderkrebsforschung forscht hauptsächlich auf dem Gebiet der Mikrobiologie und der myeloischen Leukämien. So wurden neue diagnostische Assays und Methoden, die aus unserer F&E-Arbeit hervorgegangen sind, erfolgreich an unsere diagnostische Serviceeinrichtung Labdia Labordiagnostik übertragen. Ein großer Teil unserer Arbeit konzentriert sich auf Komplikationen durch Infektionen bei onkologischen Patienten, die sich einer allogenen Stammzelltransplantation oder Chemotherapie unterziehen. Eine frühe und sichere Diagnose ist hierbei eine wesentliche Voraussetzung für die erfolgreiche Therapie. Wir haben daher für viele pathogene Viren und klinisch relevante Pilzarten quantitative molekulare Nachweisverfahren entwickelt und zum Teil patentiert. Wir konnten zeigen, dass die klinische Umsetzung verschiedener in unserer Abteilung entwickelter Methoden eine frühzeitige Einschätzung drohender infektiöser Komplikationen erlaubt und die Grundlage für eine optimierte Diagnostik darstellt. In einem aktuellen europäischen Projekt, das von unserer Gruppe koordiniert wurde, konnten wir beweisen, dass molekulardiagnostische Ansätze zu verbesserten Behandlungsstrategien gegen lebensbedrohliche Infektionen bei schwer immunsupprimierten Patientinnen und Patienten beitragen.
Die KMU Labdia Labordiagnostik GmbH wurde im Jahr 2006 als gemeinnützige Tochtergesellschaft der St. Anna Kinderkrebsforschung mit dem Ziel gegründet, neue innovative diagnostische Ansätze zu entwickeln und anzubieten. Die Hauptbereiche unserer Tätigkeit sind Hämatologie / Onkologie und Infektiologie.
In enger Zusammenarbeit mit der St. Anna Kinderkrebsforschung und anderen nationalen und internationalen Forschungszentren etablieren und validieren wir kontinuierlich neue Assays und führen diese in die klinische Diagnostik ein. Alle angebotenen diagnostischen Tests, die zum Teil patentiert wurden, basieren auf unserer eigenen Forschung und Entwicklung
„Miterlebte Todesfälle von Kindern aufgrund von Virus- oder Pilzinfektion motivierten mich, einen großen Teil meiner Foschung dieser Problematik zu widmen.“
Univ. Prof. DDr. Thomas Lion, MSc
Gruppenleiter
Wir erforschen derzeit:
Wir arbeiten aktiv in nationalen und internationalen Gremien mit, die sich mit der Standardisierung verschiedener diagnostischer Methoden befassen, und haben in, von der Europäischen Kommission geförderten, Projekten internationale Aktivitäten auf dem Gebiet der diagnostischen Entwicklung koordiniert. Durch die etablierte Vernetzung mit anderen führenden diagnostischen Zentren in Europa, die regelmäßige Teilnahme an nationalen und internationalen Ringversuchen und die enge Verzahnung mit Forschung und Entwicklung hat Labdia Zugang zu neuestem technischem Know-how und bietet hohe Kompetenz in der Spezialdiagnostik. Zu den wichtigsten diagnostischen Methoden, die Labdia derzeit anbietet, gehören molekulargenetische Tests, zytogenetische Analysen, Fluoreszenz-in-situ-Hybridisierungs (FISH)-Assays, pharmakokinetische Analysen, Durchflusszytometrie und Zellsortierung mittels FACS sowie die Untersuchung von DNA-Mutationen mittels verschiedener Techniken. Labdia ist ein international zertifiziertes Kompetenzzentrum für die umfassende Diagnostik von pädiatrischen soliden Tumoren und akuten Leukämien sowie der chronischen myeloischen Leukämie (CML), die einen wichtigen Schwerpunkt innerhalb unseres diagnostischen Spektrums darstellt. Das aktuelle Angebot an diagnostischen Tests umfasst außerdem vererbbare genetische Erkrankungen.